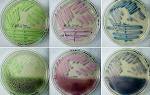

Бактериальная инфекция
Инфекционные болезни горла, вызванные бактериями, проявляются более выраженной симптоматикой, чем вирусные инфекции. Наиболее часто такие заболевания возникают из-за активации стафилококков, стрептококков, гемофильной палочки или пневмококков.
Стрептококки обычно обитают в организме человека, не вызывая заболеваний. Однако при снижении иммунной защиты, например, из-за переохлаждения, обострения хронических заболеваний или аллергии, условно-патогенные микроорганизмы начинают активно размножаться.
Эти возбудители могут привести к таким заболеваниям, как скарлатина, краснуха, корь, коклюш, ангина или рожистое воспаление. Если не начать лечение вовремя, могут возникнуть серьезные осложнения, такие как:
- отит (воспаление среднего уха);
- синуситы (воспаление околоносовых пазух);
- заглоточный абсцесс (как следствие запущенной ангины);
- бронхит, пневмония;
- лимфаденит;
- эндокардит, миокардит;
- гломерулонефрит;
- полиартрит;
- менингит;
- сепсис;
- остеомиелит.
Осложнения возникают, когда инфекции горла переходят в генерализованную форму. Это приводит к распространению патогенных микроорганизмов с кровотоком и образованию инфекционных очагов в внутренних органах. Токсины, выделяющиеся при этом, могут повреждать сердечную мышцу, почечную ткань, суставы, элементы крови и кожу.
Стрептококк передается воздушно-капельным путем, через предметы обихода, грязные руки и при кашле от заболевшего человека. Бактериальная инфекция горла часто проявляется ангиной, для которой характерны:
- высокая температура;
- сильная боль при глотании;
- налеты на миндалинах;
- гнойные фолликулы в миндалинах;
- гнойное отделяемое в лакунах;
- общее недомогание;
- снижение аппетита.
При развитии осложнений могут наблюдаться:
- боль в ухе и снижение слуха – признак отита;
- тяжесть за грудиной и перебои в работе сердца – при миокардите или эндокардите;
- боль в суставах и ограничение их подвижности – при полиартрите;
- боль в пояснице и при мочеиспускании – при поражении почек;
- боль в шее и образование гнойной полости – при абсцессах или флегмонах.
Диагностика инфекции в горле осуществляется с помощью анализа мазков из зева. Под микроскопом или при бактериологическом исследовании определяется вид патогенных микроорганизмов и их чувствительность к антибиотикам.
Стафилококк включает несколько видов (золотистый, эпидермальный и сапрофитный) и относится к условно-патогенной флоре, которая может вызвать заболевание только при определенных условиях. Заражение происходит от больного человека через воздух, пыль или предметы обихода.
Этот возбудитель может вызывать ангину, тонзиллит, кожные заболевания (фурункулез, пиодермию), воспаления дыхательной системы и кишечника, абсцесс мозга, сепсис или поражать внутренние органы, создавая в них инфекционные очаги.
Симптомы включают боль в горле при глотании, лихорадку, кашель и признаки интоксикации.
Для диагностики достаточно провести ИФА, исследовать мазки из зева и выполнить бакпосев, который позволит вырастить культуру стафилококков.
Врачи отмечают, что инфекционные заболевания горла представляют собой серьезную проблему, особенно в холодное время года. Наиболее распространенными из них являются фарингит, тонзиллит и ларингит. Специалисты подчеркивают, что эти заболевания могут быть вызваны как вирусами, так и бактериями, что требует различного подхода к лечению. Врачам важно правильно диагностировать тип инфекции, чтобы избежать ненужного назначения антибиотиков, которые эффективны только при бактериальных инфекциях.
Кроме того, медики акцентируют внимание на профилактике: регулярное мытье рук, избегание контакта с больными и поддержание иммунной системы в тонусе могут значительно снизить риск заражения. В случае появления симптомов, таких как боль в горле, высокая температура или затрудненное глотание, рекомендуется незамедлительно обратиться к врачу для получения квалифицированной помощи.

Грибковые болезни
Грибковая инфекция в области горла часто приводит к фарингомикозу, который считается хроническим заболеванием из-за сложности лечения. Грибки также могут вызывать риномикоз, отомикоз или ларингомикоз.
Чаще всего причиной этих заболеваний являются грибы рода Кандида, но не исключено поражение плесневыми грибами. Некоторые из них могут быть частью условно-патогенной флоры и обычно присутствуют на слизистых оболочках.
Факторы, способствующие активации грибков, включают длительный прием антибиотиков, кариес, хронические заболевания носоглотки и зева, диабет, а также временное снижение иммунной защиты после переохлаждения или обострения хронических недугов.
Грибковые инфекции в горле могут проявляться следующими симптомами:
- творожистым налетом на слизистой оболочке ротоглотки;
- ощущением сухости во рту;
- жжением.
Для диагностики используется микроскопическое исследование.
| Заболевание | Возбудитель | Симптомы |
|---|---|---|
| Ангина (острый тонзиллит) | Стрептококк группы А, вирусы (аденовирусы, риновирусы, вирусы гриппа и др.), грибы | Боль в горле, покраснение и отек миндалин, гнойные пробки на миндалинах (при стрептококковой ангине), высокая температура, головная боль, слабость |
| Фарингит | Вирусы (риновирусы, аденовирусы, вирусы гриппа и др.), бактерии (стрептококки, стафилококки), грибы | Боль в горле, першение, сухость, покраснение задней стенки глотки, кашель |
| Ларингит | Вирусы (риновирусы, аденовирусы, вирусы гриппа и др.), бактерии, раздражающие вещества | Хрипота, осиплость голоса, кашель, иногда боль в горле |
| Скарлатина | β-гемолитический стрептококк группы А | Высокая температура, ярко-красная сыпь на теле, белый налет на языке («малиновый язык»), ангина |
| Дифтерия | Corynebacterium diphtheriae | Налет на миндалинах и задней стенке глотки, затрудненное дыхание, слабость, высокая температура |
Вирусная патология
Инфекционное поражение горла может быть вызвано вирусами. Когда вирус попадает в организм, он начинает активно размножаться, что приводит к появлению характерных симптомов:
- заложенность носа и ринорея;
- общая слабость и ломота в теле;
- температура (обычно ниже, чем при бактериальных инфекциях);
- боль в горле;
- слезотечение;
- чихание;
- общее недомогание.
Вирусы передаются воздушно-капельным путем, например, при чихании или поцелуях. Также возможно заражение через предметы обихода.
Риск заражения вирусами значительно возрастает в закрытых, плохо проветриваемых помещениях, особенно при контакте с инфицированным человеком.
Чтобы отличить вирусную инфекцию от бактериальной, достаточно провести анализ мазков из горла или носа.
Особое внимание стоит уделить герпетической инфекции, часто встречающейся у детей. Она может вызывать стоматит или ангину. У взрослых инфекция проявляется высыпаниями на губах, носу или глазах.
Симптомы возникают после активации вируса герпеса первого типа, как при первичном заражении, так и при обострении на фоне снижения иммунной защиты. У детей могут наблюдаться:
- мышечные боли;
- субфебрильная температура;
- боль в горле, ушах или глазах;
- пузырьковые высыпания.
Иммунная система ребенка, как правило, справляется с вирусной инфекцией за 10-14 дней, в то время как бактериальные инфекции могут оставлять остаточные симптомы (кашель, легкая гнусавость голоса) еще на неделю.
Обзор инфекционных заболеваний горла вызывает множество обсуждений среди пациентов и медицинских специалистов. Многие отмечают, что информация о симптомах и методах лечения помогает лучше понять свое состояние. Пользователи в интернете делятся личным опытом, рассказывая о том, как справлялись с ангиной или фарингитом, и какие препараты оказались наиболее эффективными. Врачебные рекомендации также играют важную роль: пациенты ценят советы по профилактике и укреплению иммунной системы. Однако некоторые выражают недовольство по поводу недостатка доступной информации о редких инфекциях. В целом, обсуждение этой темы способствует повышению осведомленности и помогает людям быстрее обращаться за медицинской помощью.

Лечение инфекции
При подтверждении инфекции в горле лечение подбирается в зависимости от типа возбудителя. В случае бактериального заболевания выполняется бактериальный посев образца из ротоглотки, что позволяет определить чувствительность микроорганизмов к антибиотикам. На основании данных антибиотикограммы назначаются следующие группы препаратов:
- пенициллины – Аугментин, Флемоклав, Амоксициллин;
- цефалоспорины – Цефепим, Цефуроксим, Цефатаксим;
- макролиды – Сумамед, Азитрокс, Клацид.
Антибактериальные средства могут применяться в форме таблеток, порошков для внутримышечного или растворов для внутривенного введения. Выбор препарата принимает только врач, основываясь на тяжести заболевания.
При вирусной инфекции не следует использовать антибиотики, как это часто делают при температуре 38 градусов. Во-первых, антибиотики не действуют на вирусы, а во-вторых, их бесконтрольное применение может привести к устойчивости микроорганизмов к этим препаратам. В результате в более серьезных случаях бактериальной инфекции антибиотики могут оказаться неэффективными.
Лечение вирусных заболеваний горла должно включать противовирусные препараты, такие как Цитовир-3, Ремантадин, Амиксин, Арбидол и Афлубин. Некоторые из этих средств обладают иммуномодулирующим эффектом, что также важно при болезни. При грибковых инфекциях слизистых оболочек могут быть назначены Флуконазол, Интраконазол или Пимафуцин. Длительность курса лечения определяется врачом на основе результатов обследования.
Местное лечение может осуществляться с помощью:
- растворов для полоскания ротоглотки – Мирамистин, Фурацилин, Хлоргексидин;
- спреев для орошения слизистой горла и миндалин – Биопарокс, Гивалекс, Каметон, Ингалипт, Хлорофиллипт, Тантум Верде;
- таблеток для рассасывания – Фалиминт, Фарингосепт, Декатилен, Стрепсилс.
Также можно использовать отвары трав (ромашки, коры дуба, шалфея) для приготовления растворов для полоскания или проводить ингаляции. Важно помнить о витаминотерапии, регулярном проветривании, влажной уборке в помещении, сбалансированном питании и достаточном питьевом режиме.
Инфекционные поражения горла встречаются довольно часто, поэтому важно незамедлительно начинать лечение, чтобы избежать хронизации инфекционно-воспалительного процесса. Это особенно актуально для родителей, поскольку полное выздоровление ребенка поможет избежать необходимости операции по удалению гланд или аденоидов.
Вопрос-ответ

Какие основные симптомы инфекционных заболеваний горла?
Основные симптомы инфекционных заболеваний горла включают боль в горле, затрудненное глотание, покраснение и отек слизистой оболочки, а также возможное повышение температуры тела. В некоторых случаях могут наблюдаться налеты на миндалинах и увеличение лимфатических узлов.
Как диагностируются инфекционные заболевания горла?
Диагностика инфекционных заболеваний горла обычно начинается с физического осмотра врача, который оценивает состояние горла и лимфатических узлов. Для уточнения диагноза могут быть назначены лабораторные тесты, такие как мазок из горла на наличие бактерий или вирусов, а также анализы крови.
Какие методы лечения применяются при инфекционных заболеваниях горла?
Лечение инфекционных заболеваний горла зависит от их причины. В случае бактериальной инфекции могут быть назначены антибиотики, тогда как вирусные инфекции обычно лечатся симптоматически с помощью противовоспалительных средств, полоскания горла и обильного питья. Важно также соблюдать постельный режим и избегать раздражающих факторов.
Советы
СОВЕТ №1
Регулярно мойте руки с мылом, особенно перед едой и после посещения общественных мест. Это поможет снизить риск передачи инфекций, которые могут вызвать заболевания горла.
СОВЕТ №2
Обратите внимание на симптомы. Если вы испытываете боль в горле, затрудненное глотание или лихорадку, не откладывайте визит к врачу. Раннее обращение за медицинской помощью может предотвратить осложнения.
СОВЕТ №3
Поддерживайте иммунную систему, употребляя разнообразные продукты, богатые витаминами и минералами. Фрукты, овощи и достаточное количество жидкости помогут вашему организму бороться с инфекциями.
СОВЕТ №4
Избегайте контакта с людьми, у которых есть симптомы инфекционных заболеваний. Если вы сами заболели, оставайтесь дома, чтобы не распространять инфекцию и дать организму возможность восстановиться.